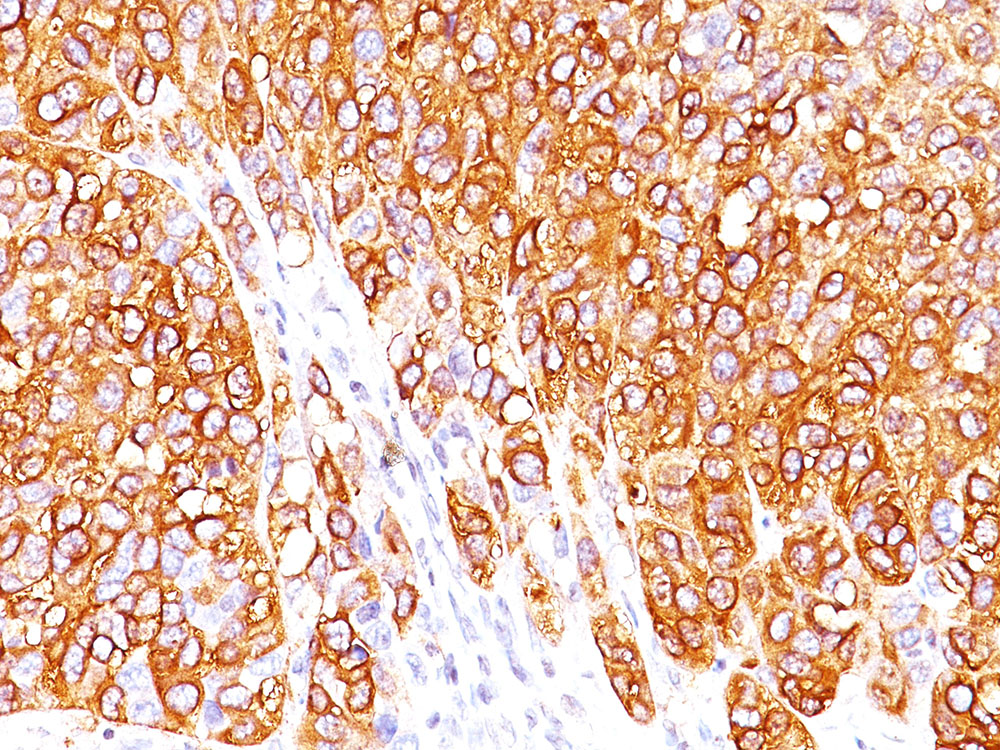

> Antigen, Antibodies, ELISA, Western Blot > Primary Antibody > Monoclonal Antibodies > MART-1 / Melan-A / MLANA (Melanoma Marker) Antibody - With BSA and AzideBrand |
Leading Biology | Catalog Number |
AMM00157G |
Product Type |
Monoclonal Antibodies | Field of Research |
|
Product Overview |
We constantly strive to ensure we provide our customers with the best antibodies. As a result of this work we offer this antibody in purified format.
We are in the process of updating our datasheets. If you have any questions regarding this update, please feel free to contact our technical support team.
This product is a high quality MART-1 / Melan-A / MLANA (Melanoma Marker) Antibody - With BSA and Azide.
|
||
Molecular Weight |
20-22kDa (doublet)
|
||
Cellular Localization |
Antigen Cellular Localization:
Endoplasmic reticulum membrane; Single-pass type III membrane protein. Golgi apparatus. Golgi apparatus, trans-Golgi network membrane. Melanosome. Note=Also found in small vesicles and tubules dispersed over the entire cytoplasm. A small fraction of the protein is inserted into the membrane in an inverted orientation. Inversion of membrane topology results in the relocalization of the protein from a predominant Golgi/post- Golgi area to the endoplasmic reticulum. Melanoma cells expressing the protein with an inverted membrane topology are more effectively recognized by specific cytolytic T-lymphocytes than those expressing the protein in its native membrane orientation
|
||
Host |
Mouse
|
||
Species Reactivity |
Human
|
||
Target |
Recombinant hMART-1 protein
|
||
Clone |
M2-7C10
|
||
Isotype |
IgG2b, kappa
|
||
Symbol |
MART1
|
||
GeneID |
|||
UniProt ID |
|||
Function |
Involved in melanosome biogenesis by ensuring the stability of GPR143. Plays a vital role in the expression, stability, trafficking, and processing of melanocyte protein PMEL, which is critical to the formation of stage II melanosomes.
|
||
Summary |
This antibody recognizes a protein doublet of 20-22kDa, identified as MART-1 (Melanoma Antigen Recognized by T cells 1) or Melan-A. MART-1 is a newly identified melanocyte differentiation antigen recognized by autologous cytotoxic T lymphocytes. Seven other melanoma associated antigens recognized by autologous cytotoxic T cells include MAGE-1, MAGE-3, tyrosinase, gp100, gp75, BAGE-1, and GAGE-1. Subcellular fractionation shows that MART-1 is present in melanosomes and endoplasmic reticulum. This MAb labels melanomas and other tumors showing melanocytic differentiation. It is also a useful positive-marker for angiomyolipomas. It does not stain tumor cells of epithelial, lymphoid, glial, or mesenchymal origin.
|
||
Form |
Liquid. Purified antibody supplied in 1x PBS buffer with 0.09% (w/v) sodium azide and 2% sucrose. |
||
Storage & Stability |
Store at +4°C short term. For long-term storage, aliquot and store at -20°C or below. Stable for 12 months at -20°C. Avoid repeated freeze-thaw cycles.
|
||
Applications |
WB, IHC, IF, FC, IP, E
|
||
Images |

Formalin-paraffin human melanoma stained with MART-1 Ab (M2-7C10). Note cytoplasmic staining of cells.
Formalin-paraffin human melanoma stained with MART-1 Ab (M2-7C10). Note cytoplasmic staining of cells. |
||
Specification |
|||
Quantity |
|
||
| Select | Brand | Catalog No. | Product Name | Pack Size | Type | Field of Research | Specification | Quantity | Price(USD) | |
| 1 | Leading Biology | APG02467G | CCK4 / PTK7 Antibody (clone 4F9) | 50 μl | Monoclonal Antibodies |
|
$495.00 | Add Ask | ||
| 2 | Leading Biology | AMM04683G | GALT Antibody (clone 4C11) | 50 μg | Monoclonal Antibodies |
|
$545.00 | Add Ask | ||
| 3 | Leading Biology | AMM01402G | Vimentin (Mesenchymal Cell Marker) Antibody - With BSA and Azide | 50 ug | Monoclonal Antibodies |
|
$395.00 | Add Ask | ||
| 4 | Leading Biology | APR08280G | LTA4H / LTA4 Antibody (clone 9G8) | 50 μl | Monoclonal Antibodies |
|
$495.00 | Add Ask | ||
| 5 | Leading Biology | AMM00172G | CD1a / HTA1 (Mature Langerhans Cells Marker) Antibody - With BSA and Azide | 50 ug | Monoclonal Antibodies |
|
$395.00 | Add Ask | ||
| 6 | Leading Biology | AMM05750G | CEBPA Antibody | 100 μl | Monoclonal Antibodies |
|
$545.00 | Add Ask |
 Leading Biology Inc.
2600 Hilltop DR, Building G, B Suite C138
Richmond, CA, 94806
Tel: 1-661-524(LBI)-0262
Email: info@leadingbiology.com
Leading Biology Inc.
2600 Hilltop DR, Building G, B Suite C138
Richmond, CA, 94806
Tel: 1-661-524(LBI)-0262
Email: info@leadingbiology.com
Complete this form and click send to ask us a question, request a quote or simply say hello.

You have 0 item in your cart

You have 0 item in your inquiry list
